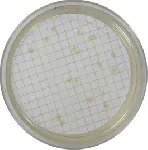

MICROINSTANT® CHROMOGENIC MEDIA SCHARLAU
Chromogenic culture media are a special class of media used in microbiology to identify microorganisms based on the colour of the colonies they form. The colour comes from substances in the media that interact with specific metabolic pathways in the microorganism(s) to be identified. Scharlau Microinstant® chromogenic media provide innovative solutions designed to improve and simplify traditional culture techniques by facilitating the visual identification of bacterial strains and reducing response times.


 Rest of the World
Rest of the World